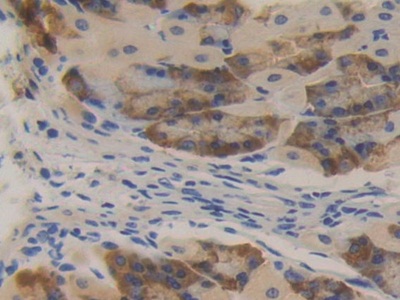
https://d1vffmuvmgkypt.cloudfront.net/image/ridacom_ltd/cloud_clone_corp/PRODUCT_SOURCE__CLOUD_CLONE__SUPPLIER__RIDACOM__ID__PAA510Mu01__2

Antigen
PRKD2
Reactivity
Human
(9)
Mouse
(9)
Rat
(6)
Research area
Enzyme & Kinase
(4)
Hepatology
(4)
Application
Western Blotting
(11)
ELISA
(8)
IHC-P
(4)
Immunocytochemistry
(2)
Immunohistochemistry
(2)
Positive Control
(2)
SDS-PAGE
(2)
Immunofluorescence
(1)
Immunoprecipitation
(1)
Antigen
PRKD1
(2)
PRKD3
(2)
Supplier
Abbkine Scientific Co., Ltd.
(5)
Cloud-Clone Corp.
(4)
Affinity Biosciences
(2)
Category
Antibodies
(9)
Cell biology
(2)
Immunochemicals
(2)
Protein Biochemistry
(2)

Antigen:
Protein Kinase D2
Synonyms: PRKD2; PRK-D2; PRKD-2; PK-D2; HSPC187; nPKC-D2; Serine/threonine-protein kinase D2
Reactivity:Mouse
Application:Positive Control; SDS-PAGE; Western Blotting
Research area:Enzyme & Kinase; Hepatology
Preparation method:Escherichia coli
| 10µg | $182.00 | |
| 50µg | $456.00 | |
| 200µg | $912.00 |
| 1mg | $2,736.00 | |
| 5mg | $6,840.00 |

Antigen:
Protein Kinase D2
Synonyms: PRKD2; PRK-D2; PRKD-2; PK-D2; HSPC187; nPKC-D2; Serine/threonine-protein kinase D2
Reactivity:Human
Application:Positive Control; SDS-PAGE; Western Blotting
Research area:Enzyme & Kinase; Hepatology
Preparation method:Escherichia coli
| 10µg | $168.00 | |
| 50µg | $420.00 | |
| 200µg | $840.00 |
| 1mg | $2,520.00 | |
| 5mg | $6,300.00 |
PRKD2 Antibody
$280.00

Antigen:
Serine/threonine-protein kinase D2
Synonyms: nPKC-D2; KPCD2_HUMAN; B4DTS2; M0QZW1; M0R2R2; Q8NCK8; Q8TB08; Q9BZL6; Q9P0T6; Q9Y3X8
Host:Rabbit
Reactivity:Human; Mouse
Application:Western Blotting; ELISA
Isotype:IgG
Clonality:Polyclonal
Aliases:DKFZp586E0820; HSPC187; KPCD2_HUMAN; nPKC D2; nPKC-D2; PKD2; PRKD 2; Prkd2; Protein kinase D2; Serine/threonine protein kinase D2; Serine/threonine-protein kinase D2
| 100μl | $280.00 |
| 200μl | $350.00 |
PKD1/2/3 Antibody
$280.00

Antigen:
Serine/threonine-protein kinase D2
Synonyms: nPKC-D2; KPCD2_HUMAN; B4DTS2; M0QZW1; M0R2R2; Q8NCK8; Q8TB08; Q9BZL6; Q9P0T6; Q9Y3X8
Host:Rabbit
Reactivity:Human; Mouse; Rat
Application:Western Blotting; ELISA
Isotype:IgG
Clonality:Polyclonal
Aliases:DKFZp586E0820; HSPC187; KPCD2_HUMAN; nPKC D2; nPKC-D2; PKD2; PRKD 2; Prkd2; Protein kinase D2; Serine/threonine protein kinase D2; Serine/threonine-protein kinase D2; KPCD1_HUMAN; nPKC D1; nPKC mu; nPKC-D1; nPKC-mu; nPKCD1; nPKCmu; PKC; PKC MU; PKCM; PKCmu; PKD 1; PKD; PKD1; PRKCM; PRKD 1; Prkd1; Protein kinase C mu; Protein kinase C mu type; Protein kinase D; Protein kinase D1; Serine/threonine protein kinase D1; Serine/threonine-protein kinase D1; EPK 2; EPK2; KPCD3_HUMAN; nPKC nu; nPKC-nu; nPKCnu; nu; PKCnu; PKD 3; PKD3; PRK D3; PRKCN; PRKD 3; Prkd3; Protein kinase C; Protein kinase C nu; Protein kinase C nu type; Protein kinase D3; Protein kinase EPK 2; Protein kinase EPK2; Serine threonine protein kinase; Serine/threonine protein kinase D3; Serine/threonine-protein kinase D3
| 100μl | $280.00 |
| 200μl | $350.00 |

Antigen:
Protein Kinase D2
Synonyms: PRKD2; PRK-D2; PRKD-2; PK-D2; HSPC187; nPKC-D2; Serine/threonine-protein kinase D2
Host:Rabbit
Reactivity:Mouse
Application:Western Blotting; Immunohistochemistry; Immunocytochemistry; Immunoprecipitation
Clonality:Polyclonal
Research area:Enzyme & Kinase; Hepatology
| 20µl | $97.00 | |
| 100µl | $227.00 | |
| 200µl | $324.00 |
| 1ml | $810.00 | |
| 10ml | $3,240.00 |

Antigen:
Protein Kinase D2
Synonyms: PRKD2; PRK-D2; PRKD-2; PK-D2; HSPC187; nPKC-D2; Serine/threonine-protein kinase D2
Host:Rabbit
Reactivity:Human
Application:Western Blotting; Immunocytochemistry; IHC-P; Immunohistochemistry; ELISA
Clonality:Polyclonal
Research area:Enzyme & Kinase; Hepatology
| 20µl | $94.00 | |
| 100µl | $220.00 | |
| 200µl | $314.00 |
| 1ml | $785.00 | |
| 10ml | $3,140.00 |
KPCD2 Polyclonal Antibody
$100.00

Antigen:
Serine/threonine-protein kinase D2
Synonyms: nPKC-D2; KPCD2_HUMAN; B4DTS2; M0QZW1; M0R2R2; Q8NCK8; Q8TB08; Q9BZL6; Q9P0T6; Q9Y3X8
Host:Rabbit
Reactivity:Human; Mouse; Rat
Application:Western Blotting; ELISA
Isotype:IgG
Clonality:Polyclonal

Antigen:
Serine/threonine-protein kinase D1
Synonyms: Protein kinase C mu type; Protein kinase D; nPKC-D1; nPKC-mu; KPCD1_HUMAN; A6NL64; B2RAF6; Q15139
Serine/threonine-protein kinase D2Synonyms: nPKC-D2; KPCD2_HUMAN; B4DTS2; M0QZW1; M0R2R2; Q8NCK8; Q8TB08; Q9BZL6; Q9P0T6; Q9Y3X8
Serine/threonine-protein kinase D3Synonyms: Protein kinase C nu type; Protein kinase EPK2; nPKC-nu; KPCD3_HUMAN; D6W587; O94806; Q53TR7; Q8NEL8
Host:Rabbit
Reactivity:Human; Mouse; Rat
Application:Western Blotting; IHC-P; ELISA
Isotype:IgG
Clonality:Polyclonal
PKD1/2/3 Polyclonal Antibody
$100.00

Antigen:
Serine/threonine-protein kinase D1
Synonyms: Protein kinase C mu type; Protein kinase D; nPKC-D1; nPKC-mu; KPCD1_HUMAN; A6NL64; B2RAF6; Q15139
Serine/threonine-protein kinase D2Synonyms: nPKC-D2; KPCD2_HUMAN; B4DTS2; M0QZW1; M0R2R2; Q8NCK8; Q8TB08; Q9BZL6; Q9P0T6; Q9Y3X8
Serine/threonine-protein kinase D3Synonyms: Protein kinase C nu type; Protein kinase EPK2; nPKC-nu; KPCD3_HUMAN; D6W587; O94806; Q53TR7; Q8NEL8
Host:Rabbit
Reactivity:Human; Mouse; Rat
Application:Western Blotting; Immunofluorescence; ELISA
Isotype:IgG
Clonality:Polyclonal
| 30μl | $100.00 | |
| 100μl | $220.00 |
| 200μl | $360.00 |
PKD2 Polyclonal Antibody
$100.00

Antigen:
Serine/threonine-protein kinase D2
Synonyms: nPKC-D2; KPCD2_HUMAN; B4DTS2; M0QZW1; M0R2R2; Q8NCK8; Q8TB08; Q9BZL6; Q9P0T6; Q9Y3X8
Host:Rabbit
Reactivity:Human; Mouse; Rat
Application:Western Blotting; IHC-P; ELISA
Isotype:IgG
Clonality:Polyclonal

Antigen:
Serine/threonine-protein kinase D2
Synonyms: nPKC-D2; KPCD2_HUMAN; B4DTS2; M0QZW1; M0R2R2; Q8NCK8; Q8TB08; Q9BZL6; Q9P0T6; Q9Y3X8
Host:Rabbit
Reactivity:Human; Mouse; Rat
Application:Western Blotting; IHC-P; ELISA
Isotype:IgG
Clonality:Polyclonal




-RPA510Hu01-000001.png)

-PAA510Hu01-000001.png)




